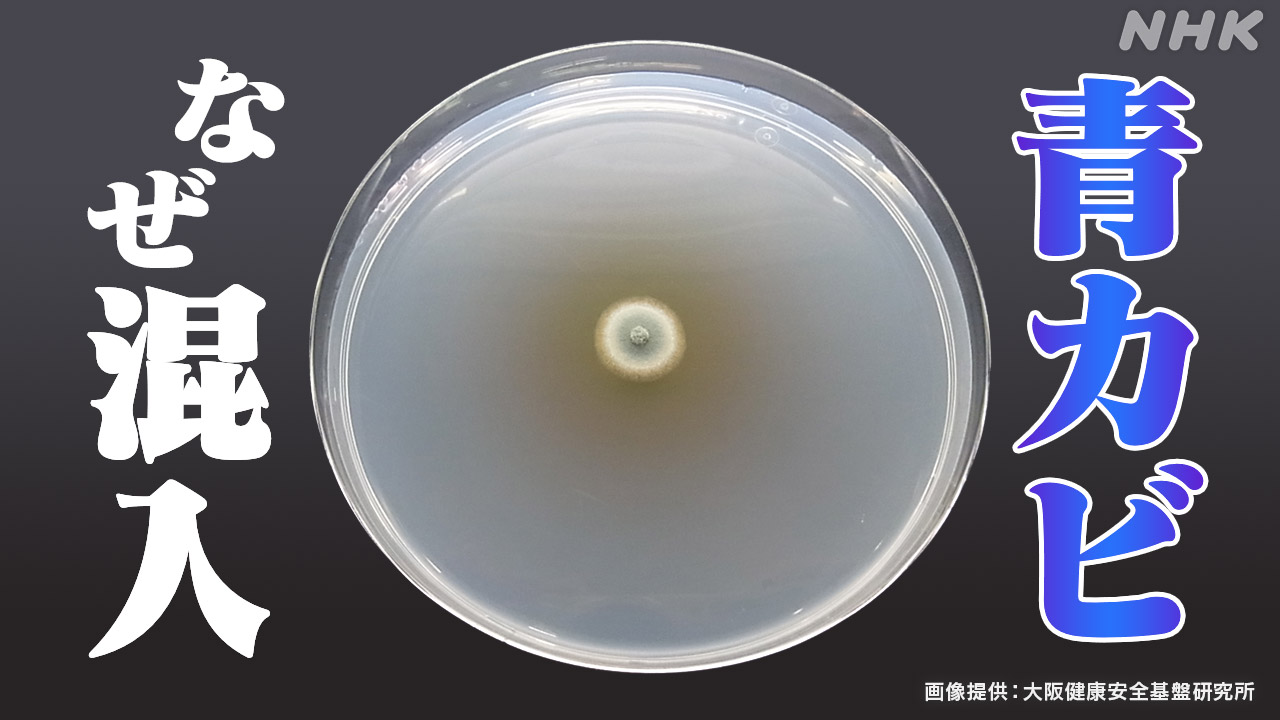

紅麹サプリに関連する死亡疑いが新たに76件も報告されているとは驚きです。被害に遭った方々やご家族には本当に心からお見舞い申し上げます。
<関連する記事>
 |
「紅麹」サプリ 新たな“死亡疑い”76件に “報告の遅れ”なぜ? 厚労相、怒りあらわ “被害”の男性…「納得いく説明を」 …「紅麹」問題で、新たに76件、死亡との因果関係を調査しています。 28日夜、news zeroは、小林製薬の「紅麹コレステヘルプ」を飲んでいたとい… (出典:日テレNEWS NNN) |
 |
小林製薬「紅麹サプリ」 新たに170件の死亡相談 …小林製薬の「紅麹サプリ」をめぐる健康被害の問題で、厚労省は死亡に関して遺族からの相談が170件あったことを明らかにしました。 小林製薬の「紅麹サプリ」を… (出典:テレビ朝日系(ANN)) |
 |
小林製薬「紅麹」問題 新たに76人の死亡との関連の疑い 武見厚労大臣「27日になって初めて全体像が示された」 …「紅麹」成分を含むサプリメントを摂取した人に健康被害が出ている問題で、新たに76人の死亡との関連が疑われる事例が明らかになりました。小林製薬は、きの… (出典:TBS NEWS DIG Powered by JNN) |